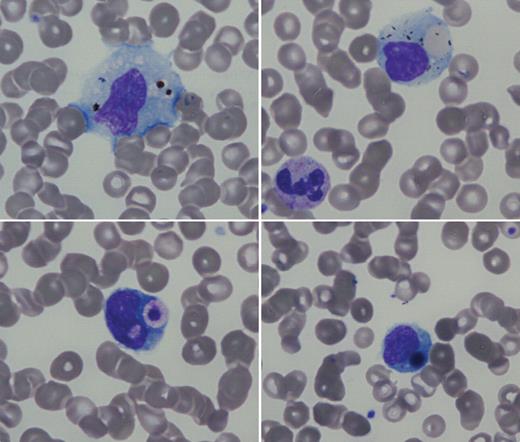
A 46-year-old man with stable HIV and hepatitis C virus chronic infection was seen for unexplained fever, headache, and vomiting after a trip to Cameroon. There were no significant physical findings. Complete blood count showed marked thrombocytopenia (28 × 109/L) and normal white blood cell count and hemoglobin. / Examination of the peripheral blood smear showed severe Plasmodium falciparum infection (parasitemia 1% and 1 schizont). In addition, there were numerous examples of hemophagocytosis on the peripheral blood smear. The top left panel shows a monocyte with particulate debris, perhaps remnants of the malarial infection. The top right panel shows a red cell engulfed by a monocyte. On the bottom left, the phagocytosed material resembles a platelet, and on the bottom right is a larger, circular, phagocytosed object that may represent an erythroblast nucleus or a giant platelet. Additional laboratory tests included triglycerides 5.29mM, ferritin 897 μg/L, and lactic dehydrogenase 278 UI/L, adding support for the hemophagocytic syndrome. After receiving intravenous quinine, he rapidly improved with correction of thrombocytopenia. / Hemophagocytic syndrome is a life-threatening disease associated with excessive stimulation of tissue macrophages. It has been noted in lymphoma, infections, or autoimmune diseases. Hemophagocytic syndrome with malaria infection has been described but without the demonstration of hemophagocytosis in the peripheral blood.

A 46-year-old man with stable HIV and hepatitis C virus chronic infection was seen for unexplained fever, headache, and vomiting after a trip to Cameroon. There were no significant physical findings. Complete blood count showed marked thrombocytopenia (28 × 109/L) and normal white blood cell count and hemoglobin.
Examination of the peripheral blood smear showed severe Plasmodium falciparum infection (parasitemia 1% and 1 schizont). In addition, there were numerous examples of hemophagocytosis on the peripheral blood smear. The top left panel shows a monocyte with particulate debris, perhaps remnants of the malarial infection. The top right panel shows a red cell engulfed by a monocyte. On the bottom left, the phagocytosed material resembles a platelet, and on the bottom right is a larger, circular, phagocytosed object that may represent an erythroblast nucleus or a giant platelet. Additional laboratory tests included triglycerides 5.29mM, ferritin 897 μg/L, and lactic dehydrogenase 278 UI/L, adding support for the hemophagocytic syndrome. After receiving intravenous quinine, he rapidly improved with correction of thrombocytopenia.
Hemophagocytic syndrome is a life-threatening disease associated with excessive stimulation of tissue macrophages. It has been noted in lymphoma, infections, or autoimmune diseases. Hemophagocytic syndrome with malaria infection has been described but without the demonstration of hemophagocytosis in the peripheral blood.
A 46-year-old man with stable HIV and hepatitis C virus chronic infection was seen for unexplained fever, headache, and vomiting after a trip to Cameroon. There were no significant physical findings. Complete blood count showed marked thrombocytopenia (28 × 109/L) and normal white blood cell count and hemoglobin.
Examination of the peripheral blood smear showed severe Plasmodium falciparum infection (parasitemia 1% and 1 schizont). In addition, there were numerous examples of hemophagocytosis on the peripheral blood smear. The top left panel shows a monocyte with particulate debris, perhaps remnants of the malarial infection. The top right panel shows a red cell engulfed by a monocyte. On the bottom left, the phagocytosed material resembles a platelet, and on the bottom right is a larger, circular, phagocytosed object that may represent an erythroblast nucleus or a giant platelet. Additional laboratory tests included triglycerides 5.29mM, ferritin 897 μg/L, and lactic dehydrogenase 278 UI/L, adding support for the hemophagocytic syndrome. After receiving intravenous quinine, he rapidly improved with correction of thrombocytopenia.
Hemophagocytic syndrome is a life-threatening disease associated with excessive stimulation of tissue macrophages. It has been noted in lymphoma, infections, or autoimmune diseases. Hemophagocytic syndrome with malaria infection has been described but without the demonstration of hemophagocytosis in the peripheral blood.
Many Blood Work images are provided by the ASH IMAGE BANK, a reference and teaching tool that is continually updated with new atlas images and images of case studies. For more information or to contribute to the Image Bank, visit http://imagebank.hematology.org.